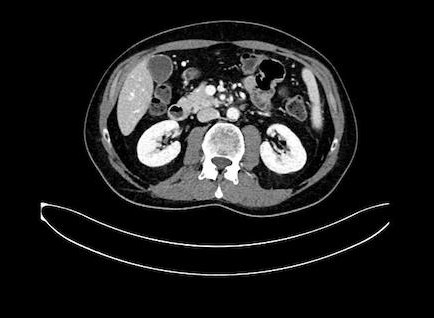

Het is D-day. Na 3 kuren van 2 weken was er een scan. Nu één dag voor de vierde ronde van deze kuur de uitslag.
Vol goede moed en met een gerust gevoel gaan we, Annie gaat natuurlijk mee, naar het Antoni van Leeuwenhoek ziekenhuis in Amsterdam.
Even aanmelden bij de aanmeldzuil en dan even langs Radiologie voor het opvragen van de foto’s. Helaas is de CD brander stuk, maar gelukkig kan het ook per e-mail. Terwijl dat in gang gezet is, gaan wij weer terug naar wachtruimte 1C waar we moeten wachten tot ze ons komen halen.
Goed op tijd worden we geroepen en mogen we met de Oncoloog en een nieuwe chirurg een hok ik voor het gesprek.
Het begint goed, want de tumor is flink (en zij waren er erg enthousiast over) geslonken. Deze mokerslag slaat dus aan! Van 3,4 naar 2,2 cm. Dat is een zeer goed resultaat na 3 kuren. (wel raar, want aan het begin werd verteld dat hij maar 2,5 cm was. Blijkbaar was hij wat groter. Al maakt dat niet zo veel uit, het gaat om het stuk langs mijn aderen.
Anyway, ze vertellen dat met enthousiasme, maar een geoefend oor hoort een ‘maar’ aankomen. En dat komt dus ook. De maar is dat de tumor wel kleiner is en het gebied langs het belangrijkste deel van de ader ook wat losser ligt, maar een groot deel niet los ligt van de ader(s) wat nodig is voor een operatie.
Nou is het zo dat als ze niet kunnen, durven of willen opereren het gewoon einde verhaal is. We warendan ook erg blij met de volgend zin, namelijk dat ze hoe dan ook gaan opereren. Het is operabel.
Daarmee zakken onze schouders wat omlaag. Maar… (het zit vol met mitsen en maren hoor) vertellen ze dat als ze nu opereren dat de kans dat het helemaal schoon wordt klein is. Te veel contact met aders en dus lastig schoon maken.
Dat is logisch en begrijpbaar, maar wel balen. Hun oplossing? Nog 4 kuren van 2 weken extra mokerslag en dan scannen. Waarschijnlijk dan ook echt opereren. Zo’n 4-6 weken aansterken eerst, maar dan is het ook zo ver (denken ze nu).
Dus goed kleiner, maar niet los, nog even doorzetten (70 dagen nog dus) en dan goede hoop op een oplossing.
Het is natuurlijk een no-brainer… 70 dagen voor 30-40 jaar (we houden het dan ook positief) is natuurlijk een ‘ja’. Het besluit valt dan ook erg snel, weg aan er voor!
Maar even wel is het wel even slikken. Heb nu al 15 weken gehad (los van de eerste ronde van 12 weken even geleden) en dan nu nog 10 weken er bij… het is wel een klap hoor. Maar ik weet waarvoor ik het doe, thuis 2 kids en een vrouw is de moeite waard, geen haar op mijn hoofd die denkt het niet te doen.
Dus weer met lood in de schoenen maar ontspannen schouders de auto in, maar niet voordat we de Oncoloog in Zoetermeer gesproken hebben om aan te geven dat de medicatie besteld kan worden en natuurlijk om te vernemen of mijn bloedwaarde van het prikken van gister goed genoeg was om weer op te mogen. Gelukkig is dat het geval en mag ik mij om 09:00 melden morgen.
De uitslag in eigen woorden (zoals gedeeld met iedereen):
“Weer een update met uitslag en vervolg…
Lang verhaal kort: de tumor is bijzonder goed geslonken (van 3,4 naar 2,2 cm) maar nog niet los genoeg van de ader die opereren lastig maakt.
Nou hebben ze wel besloten dàt ze gaan opereren, maar willen meer vrije ruimte hebben om het slagingspercentage te verbeteren.
Dat betekent komende week de kuur van 8 weken afmaken (week 7 start vandaag) en daarna nog 4 kuren van 2 weken te doen. Ergo de komende 10 weken weer di en wo infuus in ziekenhuis en do-vrij thuis infuus, afgewisseld met een rustweek/herstelweek.
Daarna scan en operatie, tenminste zo ziet het er nu uit.
Balen, maar wel fijn dat ze willen gaan snijden en gaan voor de grootste kans op volledig herstel.
❤️🩹het is niet anders🤕”
Maar er zijn ook mensen met verstand van zaken en die schrijven het zo:
—–
1 Radiology Report
1.1 Language of Content Item and Descendants
1.2 Observer Type
1.3 Person Observer Name
1.4 Findings
1.4.1 Finding
Klinische gegevens:
47-jarige man, status na resectie en neoadjuvante chemotherapie (CAPOX) van een pT3N1 dunne darmcarcinoom, met nu een lokaal recidief met betrokkenheid van de AMS als VMS. begin juli enige respons na 3x CAPOX
Vraagstelling:
Responsevaluatie na nogmaals 2 maanden FOLFOXIRI
Vergelijking: Eerdere CT onderzoeken
Bevindingen:
THORAX:
Geen verdachte intrapulmonale noduli, geen significant pleura- of pericardvocht, geen thoracale lymfadenopathie. Ongewijzigde aspecifieke millimetrische nodus in de linkerbovenkwab (serie 2, beeld 84) . Geen verdere nieuwe of voor de vraagstelling relevante nevenbevindingen
ABDOMEN:
Verdere afname van het gekend tumorrecidief tegen de jejunum naad in de linkerbovenbuik, bij meting in axiaal vlak nu ca. 2,2 cm (dit was 3.4 cm bij uitgangssituatie van maart). De AMS en VMS lopen centraal vrij, wel is er blijvend contact met centrale aftakkingen richting jejunum/linkerbuikhelft, meest uitgesproken veneus, zie (serie 503, beeld 1). Ook is er blijvend contact met het linkszijdig deel van het pars horizontale van het duodenum. Geen aanwijzingen voor viscerale, lymfogene of peritoneale metastasen. Ongewijzigd wat prominente klier van 0,7 cm links para-aortaal, bij initiële PET scan niet avide. Geen verdere nieuwe of voor de vraagstelling relevante nevenbevindingen
SKELET/WEKE DELEN:
Geen aanwijzingen voor ossale, (sub)cutane of overige weke delen metastasen
Conclusie:
Verdere afname van de gekende recidief tumor aangrenzend aan de eerdere dunne darm naad in de linkerbovenbuik, blijvend contact met centrale aftakkingen van de AMS en met name VMS; blijvend focaal contact met het duodenum
Ongewijzigd geen overtuigende lymfadenopathie of afstandsmetastasen.
—–
Om het makkelijker te maken hebben we de foto’s nog. Ook 2 gifjes, maar die zijn te groot, deze heb ik omgezet naar video’s, zodat we ik ze toch kan delen.
Nou hebben ze op een foto laten zien waar de tumor zit, daar stond ook een meet-lijn waardoor je de grootte kan zien. Hij is dus 2,2 cm en 6 weken geleden nog 3,4, het gaat dus goed. Verder houden we ons gewoon aan wat ze allemaal zeggen en gaan we gewoon mee in het advies.
Hierbij de foto’s:
Eersts voor de nerds:
Dan foto’s die voor hen blijkbaar belangrijk zijn.
(dit is mijn long, waar ze ook een puntje zin zien, maar die groeit niet en is waarschijnlijk gewoon weefsel. Toch fijn dat ze het in de gaten houden)
En dat is ook zo, want op deze foto is te zien waar hij ligt (lieten ze ons zien)
In het midden zit een mooie stip (ader) En daar schuin boven zie je nog wat lichts (ook ader). Daar tussen zit een grijze klodder… dat is ‘m. De witte delen zijn aders, en daar moet hij dus los van komen te liggen.
Nog een overzicht.
En dan natuurlijk de video’s ter vermaak.
Veel meer is er eigenlijk niet te vertellen, we gaan gewoon verder… nog maar 70 dagen…

Ik vind je heel moedig en wens je veel 🤞
Houd van je❤️❤️